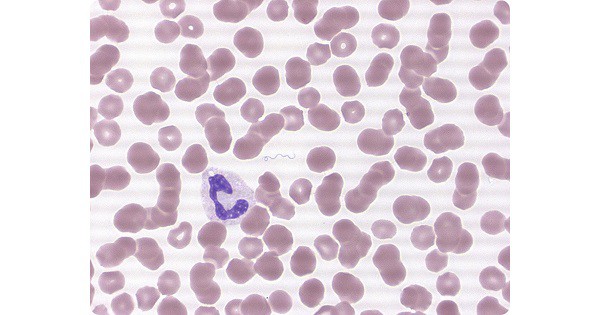
Borrelia and Relapsing Fever

Borrelia and Relapsing Fever
Introduction
- Relapsing fever is caused by spiral-shaped bacteria of the genus Borrelia and sub-species Relapsing Fever Borrelia (RFB).
- Borrelia readily undergoes antigenic variations in vivo and this is believed to be the reason for the occurrence of relapses in the disease
Relapsing Fever can be divided into
- Louse-borne relapsing fever (LBRF)
- Soft tick-borne relapsing fever and hard tick-borne relapsing fever.
Louse-borne relapsing fever
- Caused by a single Borrelia pathogen, B. recurrentis.
- The first case linked with spirochetal etiology and body louse transmission occurred in late 19th –early 20th century.
- Transmitted by louse
- No other known animal reservoir of B. recurrentis exists
Soft tick-borne relapsing fever
- First discovered to cause disease in humans in the early 20th century.
- The disease is caused by B. crocidurae, B. duttoni, B. persica, B. latyshervi, and B. hisponica, B. venezuelensis, B. mazotti, B. hermsii, B. turicatae, and B. parkeri.
Hard-tick relapsing fever
Infections are currently known to be caused by B. miyamotoi. B. miyamotoi
- Severe for most tick-borne relapsing fever; headache, neck stiffness, arthralgia, myalgia, ecchymosis, epistaxis, and petechiae.
- Complications include ARDS, decreased sensorium, myocarditis, hepatitis, abortion or stillborn and death.
Serologic laboratory testing
- ELISA or immunofluorescence assay as a screening test
- Followed by a Western blot for confirmation
- PCR
Treatment
- For decades, penicillins and tetracyclines have been the treatment of choice in relapsing fever.
Exam Important
Introduction
- Relapsing fever is caused by spiral-shaped bacteria of the genus Borrelia and sub-species Relapsing Fever Borrelia (RFB).
- Borrelia readily undergoes antigenic variations in vivo and this is believed to be the reason for the occurrence of relapses in the disease
Relapsing Fever can be divided into
Louse-borne relapsing fever
- Caused by a single Borrelia pathogen, B. recurrentis.
- Transmitted by louse
- No other known animal reservoir of B. recurrentis exists
Soft tick-borne relapsing fever
- The disease is caused by B. crocidurae, B. duttoni, B. persica, B. latyshervi, and B. hisponica, B. venezuelensis, B. mazotti, B. hermsii, B. turicatae, and B. parkeri.
Hard-tick relapsing fever
- Infections are currently known to be caused by B. miyamotoi. B. miyamotoi
Clinical manifestations
- Severe for most tick-borne relapsing fever; headache, neck stiffness, arthralgia, myalgia, ecchymosis, epistaxis, and petechiae.
- Complications include ARDS, decreased sensorium, myocarditis, hepatitis, abortion or stillborn and death.
Serologic laboratory testing
- ELISA or immunofluorescence assay as a screening test
- Followed by a Western blot for confirmation
- PCR
Treatment
- For decades, penicillins and tetracyclines have been the treatment of choice in relapsing fever.
Don’t Forget to Solve all the previous Year Question asked on Borrelia and Relapsing Fever